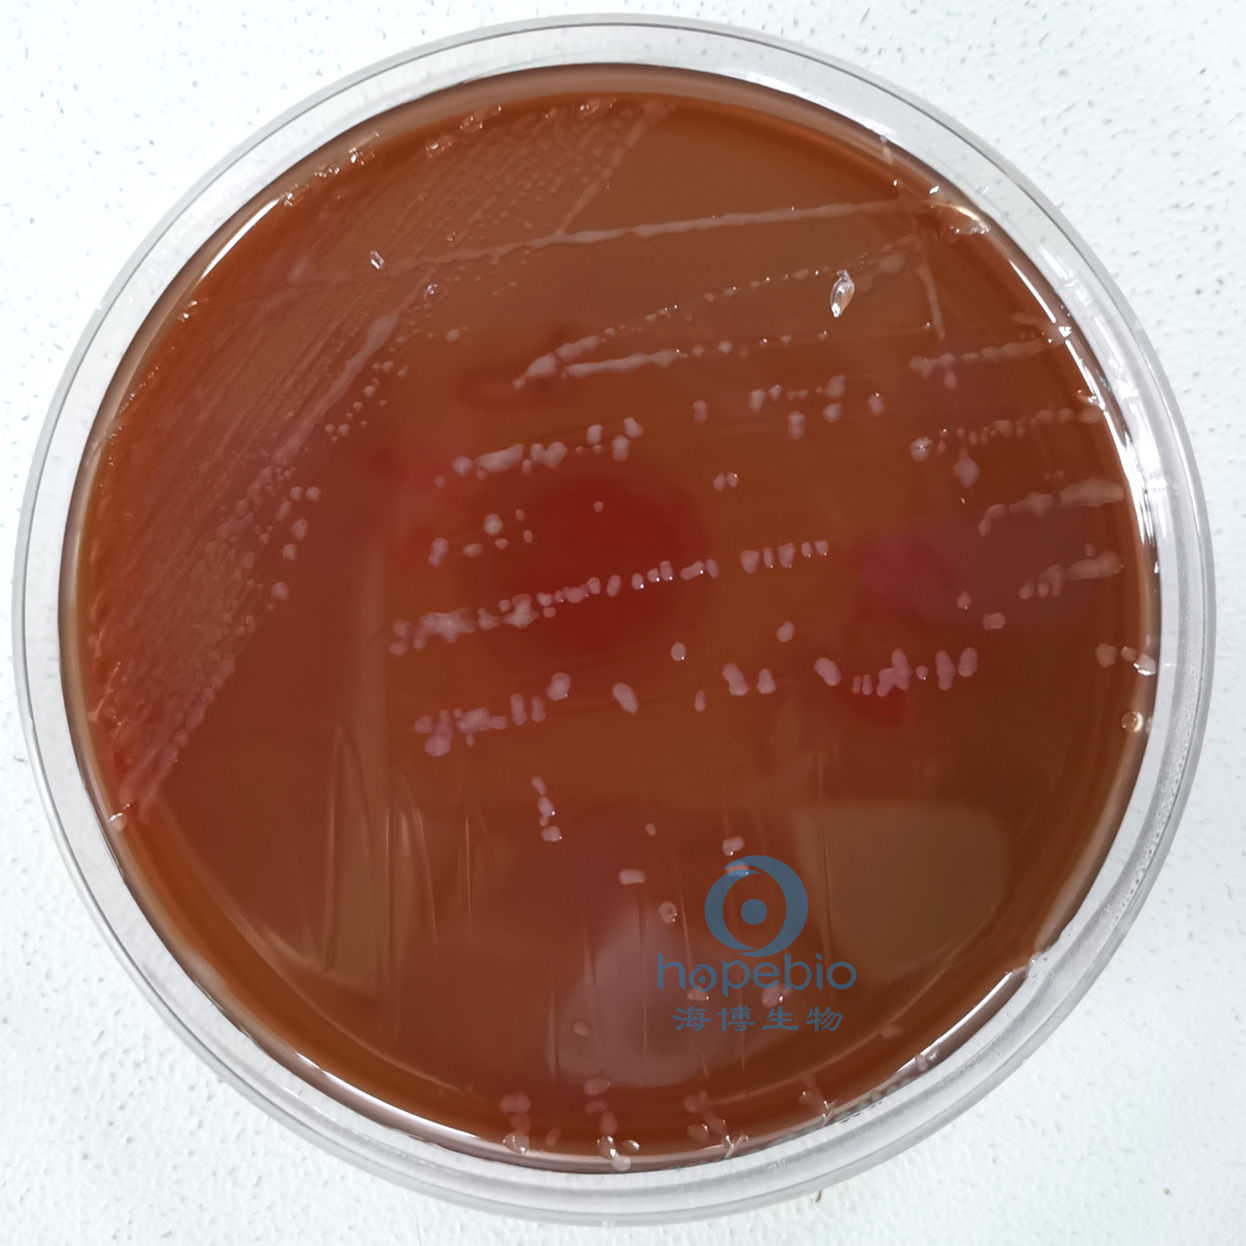
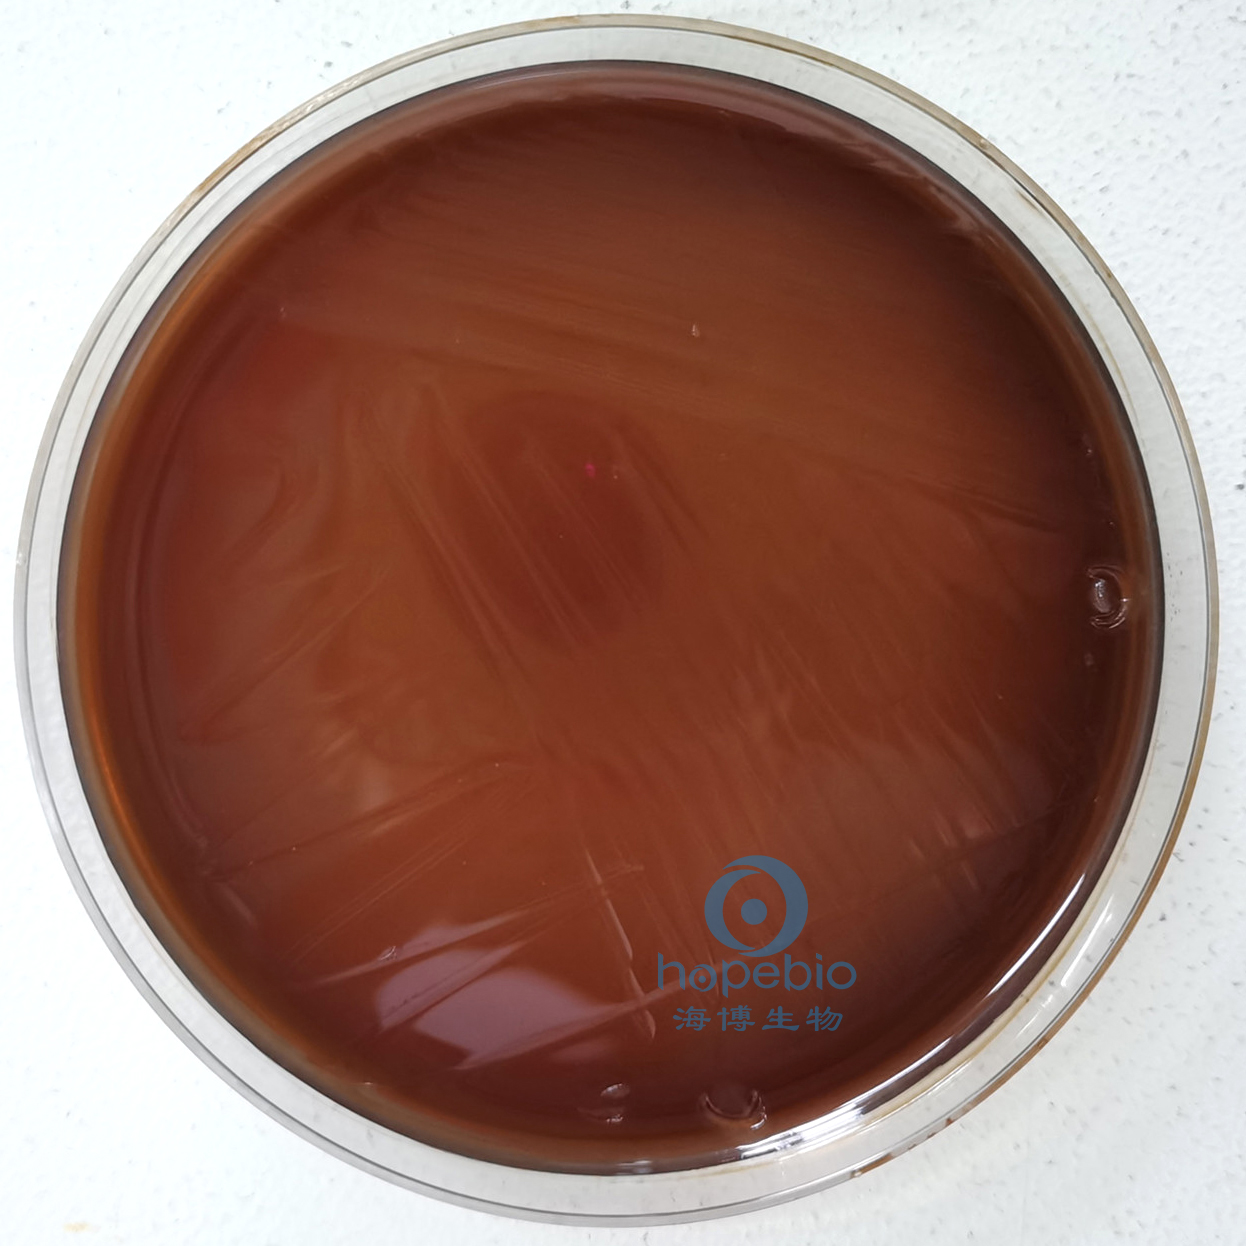
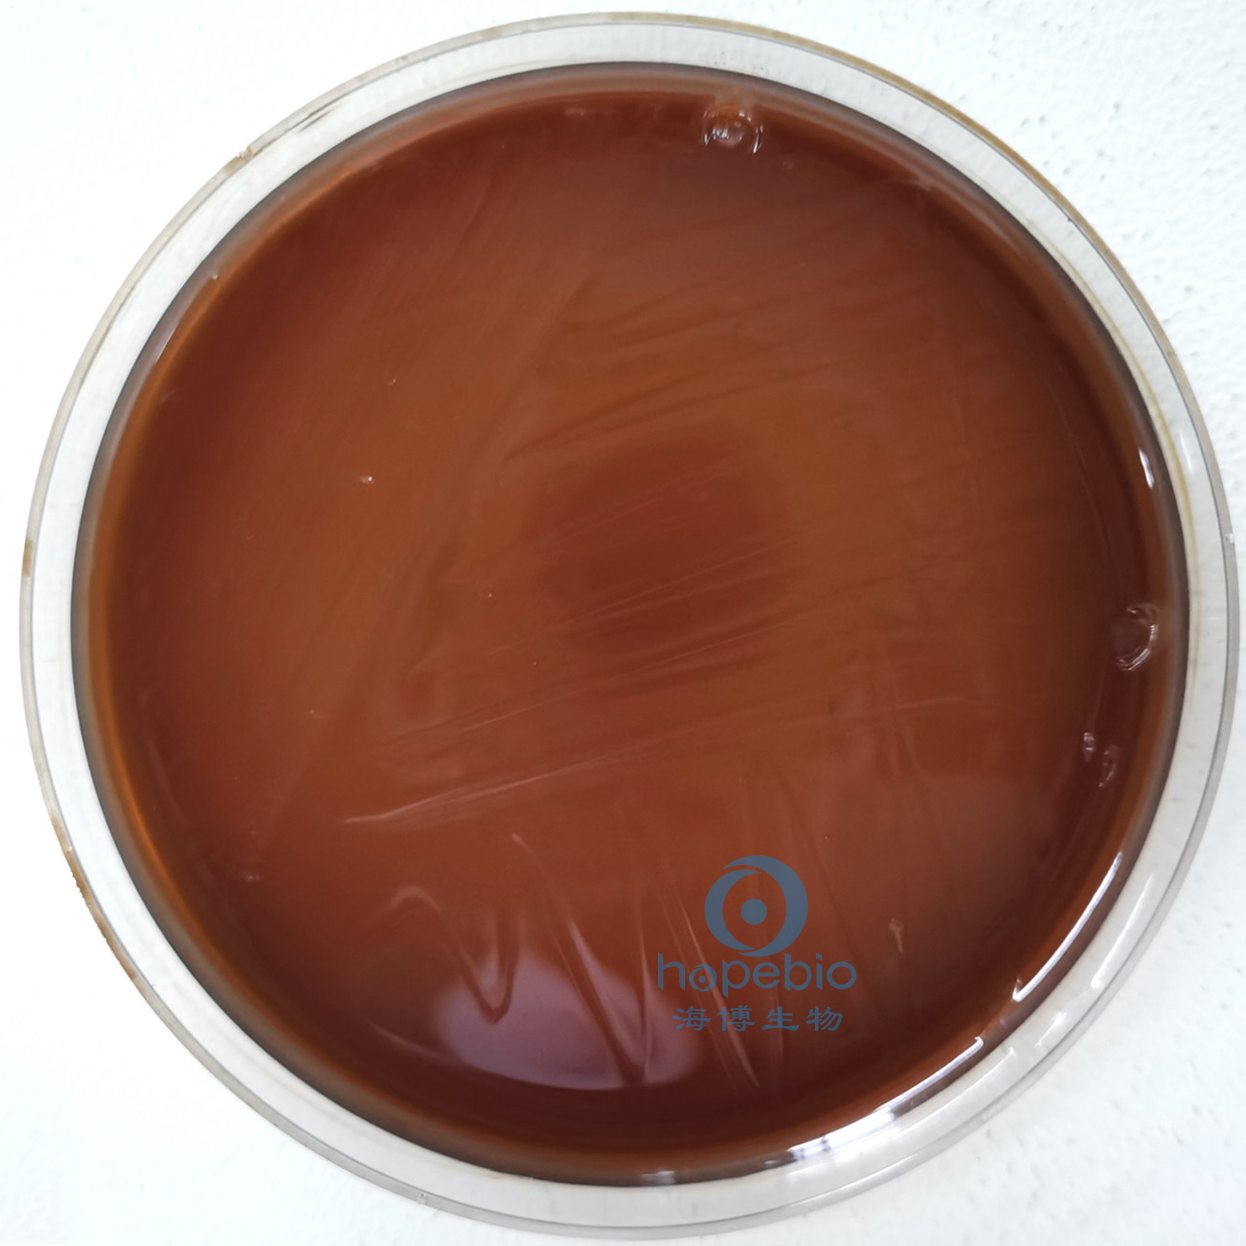

海博微信公众号
海博微信公众号
 海博天猫旗舰店
海博天猫旗舰店


 海博微信公众号
海博微信公众号
 海博天猫旗舰店
海博天猫旗舰店




一、用途
用于空肠弯曲杆菌的分离培养(GB4789.9-2014,GB4789.28-2013,ISO标准)。
二、实验原理
蛋白胨、酵母浸粉和胰酪蛋白胨提供碳源、氮源、维生素和矿物质;氯化钠提供均衡的渗透压;无菌冻融脱纤维羊血提供额外的营养物质;硫酸亚铁、焦亚硫酸钠和丙酮酸钠有利于空肠弯曲菌的生长;TMP、多粘菌素B和万古霉素可抑制样本中非弯曲菌的生长,从而便于分离空肠弯曲菌;琼脂是凝固剂。
三、培养基配方(g/L)
|
蛋白胨 |
15.0 |
|
酵母浸粉 |
5.0 |
|
胰酪蛋白胨 |
2.5 |
|
氯化钠 |
5.0 |
|
琼脂 |
15.0 |
| pH7.4±0.2 | 25℃ |
FBP溶液:丙酮酸钠、焦亚硫酸钠、硫酸亚铁各0.25g溶解于100mL纯化水中,用0.22μm微孔滤膜过滤除菌。
抗生素溶液:称取头孢哌酮0.032g,两性霉素B0.01g,利福平0.01g,溶解于5mL 50%无菌乙醇溶液中。
配制方法:称取基础培养基4.25g,加热搅拌溶解于100ml蒸馏水中,121℃高压灭菌15分钟,冷至50-55℃左右时,加入1ml过滤除菌的FBP浓原液、一支改良Skirrow氏琼脂基础添加剂1mL和无菌冻融脱纤维羊血5ml,混匀,倾入无菌平皿。
四、试验方法
1、制备质控菌液。
2、将质控菌液划线接种于平板。
3、42±1℃微需氧培养24-48小时,记录实验结果。
五、结果观察与解释
接种以下质控菌株,42±1℃微需氧培养24-48小时:
|
质控菌株 |
菌株编号 |
生长情况 |
其他特征 |
|
空肠弯曲菌 |
ATCC33291 |
+++ |
灰色扁平湿润有光泽,呈沿接种线向外扩散 |
|
大肠埃希氏菌 |
ATCC25922 |
- |
/ |
|
金黄色葡萄球菌 |
ATCC25923 |
- |
/ |
改良Skirrow氏琼脂基础质控结果:
|
|
|
|
|
|
空肠弯曲菌 灰色扁平湿润有光泽,呈沿接种线向外扩散 |
|
大肠埃希氏菌 抑制 |
|
金黄色葡萄球菌 抑制 |
六、注意事项
本培养基仅为细菌鉴定的一部分,需做其他补充试验。
相关产品:
注:本文属海博生物原创,未经允许不得转载。



